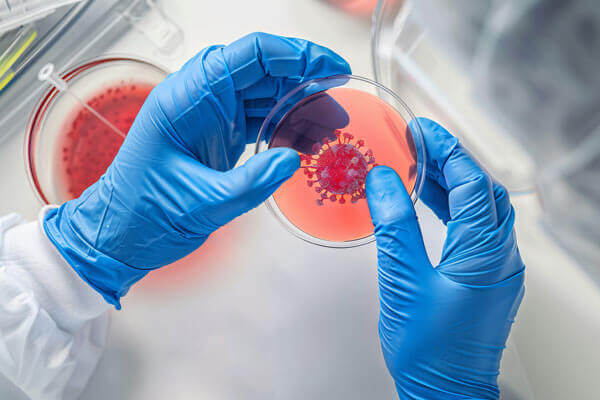
SANBS Purpose Icon

Our Strategy
How we performed in FY25 against the iHEALTh strategy

Our Strategy
How we performed in FY25 against the iHEALTh strategy
Logistics and benchmark

Aspiration
Move blood products in the value chain in a timely, effective and efficient manner
Related material matters



Contribution to long-term sustainable value




Strategic priorities
- Ensure 100% of critical consumables are available to support the value chain 100% of the time
- Investigate and implement the state of art design for mobile donor vehicles
- Optimise process cost efficiency for delivery of blood products
Target achieved / exceeded
Improvement YOY
No concerns yet
Below target
Key Measured Initiatives
| Initiative | Target | IR 2023 | IR 2024 | Progress Apr 2024 – Mar 2025 |
|---|---|---|---|---|
| Driver behaviour score |
|
|
|
|
| Blood bank courier fulfilled on time |
|
|
|
|
| NBI plasma targets met (Litres) |
|
|
|
|
Manage critical stock levels |
|
|
|
|
Testing and quality
Aspiration
Provide quality testing in an efficient manner
Related material matters



Contribution to long-term sustainable value



Strategic priorities
- Harmonise quality standards to meet international benchmarks
- SANBS products and services meet the quality control requirements at regulatory bodies and national standards to meet internal and external customer requirements
Target achieved / exceeded
Improvement YOY
No concerns yet
Below target
Key measured initiatives
| Initiative | Target | IR 2023 | IR 2024 | Progress Apr 2024 – Mar 2025 |
|---|---|---|---|---|
Blood safety index |
|
|
|
|
Accreditation |
|
|
|
|
| Meet ISO 9001 standards |
|
|
|
|
| Meet SLA TAT for standard crossmatches |
|
|
|
|
| Turnaround time for units to become available for use |
|
|
|
|

